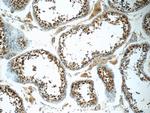
SCAPER Antibody in Immunohistochemistry (Paraffin) (IHC (P))

Search
Proteintech
SCAPER Polyclonal Antibody
{{$productOrderCtrl.translations['antibody.pdp.commerceCard.promotion.promotions']}}
{{$productOrderCtrl.translations['antibody.pdp.commerceCard.promotion.viewpromo']}}
{{$productOrderCtrl.translations['antibody.pdp.commerceCard.promotion.promocode']}}: {{promo.promoCode}} {{promo.promoTitle}} {{promo.promoDescription}}. {{$productOrderCtrl.translations['antibody.pdp.commerceCard.promotion.learnmore']}}
产品信息
16994-1-AP
种属反应
已发表种属
宿主/亚型
分类
类型
抗原
偶联物
形式
浓度
规格
纯化类型
保存液
内含物
保存条件
运输条件
产品详细信息
Immunogen sequence: MGLIDKLCA CFLSVQGPVD ENPKMAIFLQ HAAGLLHAMC TLCFAVTGRS YSIFDNNRQD PTGLTAALQA TDLAGVLHML YCVLFHGTIL DPSTASPKEN YTQNTIQVAI QSLRFFNSFA ALHLPAFQSI VGAEGLSLAF RHMASSLLGH CSQVSCESLL HEVIVCVGYF TVNHPDNQVI VQSGRHPTVL QKLCQLPFQY FSDPRLIKVL FPSLIAACYN NHQNKIILEQ EMSCVLLATF IQDLAQTPGQ AENQPYQPKG KCLGSQDYLE LANRFPQQAW EEARQFFLKK EKK (1-292 aa encoded by BC015212)
靶标信息
CCNA2/CDK2 regulatory protein that transiently maintains CCNA2 in the cytoplasm.
仅用于科研。不用于诊断过程。未经明确授权不得转售。
生物信息学
蛋白别名: Mutations: 870:OK; S phase cyclin A-associated protein in the endoplasmic reticulum; S phase cyclin A-associated protein in the ER; Zinc finger protein 291
基因别名: C430017I08; D530014O03Rik; IDDRP; KIAA1454; MSTP063; SCAPER; Zfp291; ZNF291
UniProt ID: (Human) Q9BY12
Entrez Gene ID: (Human) 49855, (Mouse) 244891